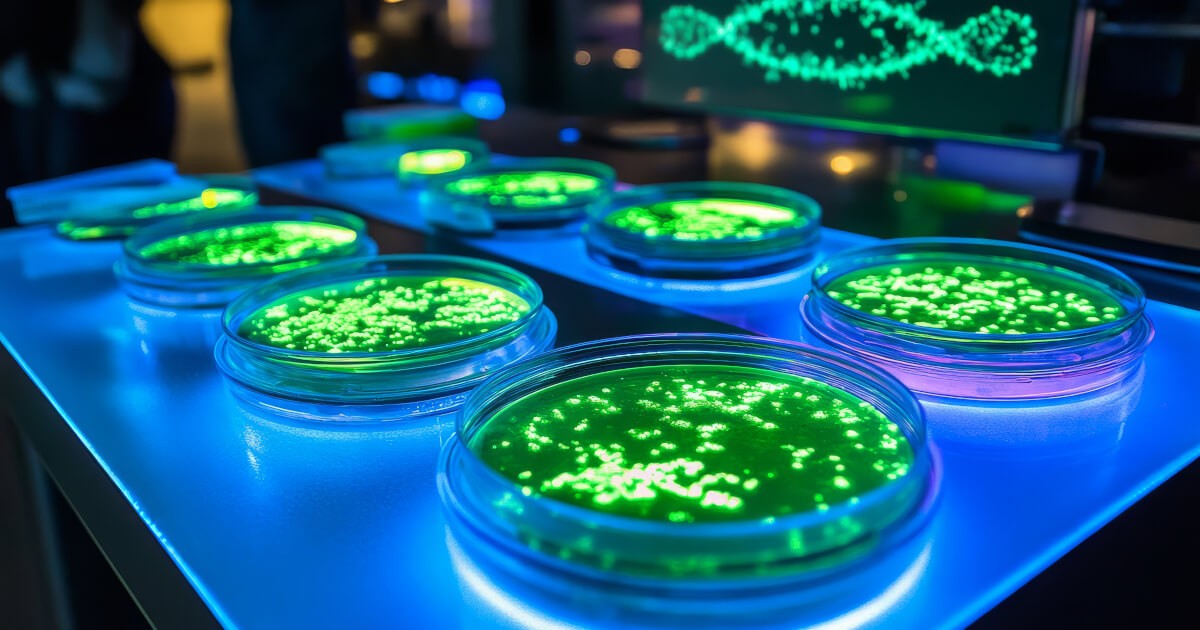

Opinii
31 mar. 2026
Șeful Cancelariei lui Bolojan dezvăluie în Senat mecanismul corupției la avizele ISU: „Toată lumea primea un avertisment și era o formă de corupție"
Mihai Jurca, șeful Cancelariei premierului Ilie Bolojan, a explicat marți, 31 martie, în fața Comisiei de Buget a Senatului, logica din spatele reformei procesului de avizare ISU introduse prin OUG 17/2026. În mijlocul unei intervenții tehnice despre termene și praguri de suprafață, Jurca a deschis subiectul corupției endemice din sistem cu o franchețe neobișnuită pentru un oficial guvernamental — și cu un vocabular care merită o discuție separată.
Ce s-a schimbat prin OUG 17/2026
Guvernul a simplificat pe 13 martie procesul de obținere a avizului și autorizației de securitate la incendiu (ISU), o cerință legală obligatorie pentru marea majoritate a construcțiilor. Jurca a prezentat senatorilor principalele modificări.
Termenele au fost standardizate și clar limitate: maximum 15 zile pentru emiterea avizului și 30 de zile pentru acord. O clauză anti-blocare stipulează că, dacă termenele sunt depășite, se emite automat un aviz temporar de 60 de zile, în care reprezentanții ISU sunt obligați să efectueze un control în teren. Scopul declarat este să nu fie blocată activitatea operatorilor economici din cauza incapacității instituționale de a procesa documentațiile la timp.
Pragul de suprafață de la care este obligatorie documentația completă a fost dublat, de la 600 mp la 1.200 mp. Potrivit estimărilor interne, această modificare va reduce volumul de documentații care ajung la ISU cu aproximativ 40%. Ulterior, prin hotărâre de guvern adoptată în 90 de zile, vor fi introduși indicatori suplimentari de risc care nu se bazează exclusiv pe suprafață — gradul de risc al unui restaurant diferind de cel al unei săli de birouri cu aceeași amprentă.
Jurca a precizat că măsurile au fost elaborate în consultare cu instituțiile implicate și cu mediul de afaceri, pe parcursul a patru luni, și că există și o presiune concretă din nevoia de a debloca investițiile din fonduri europene și PNRR pentru care avizele ISU constituiau un blocaj.
Revelația din sală: avertismentul ca instrument de corupție
Senatorul PNL Petrică Lucian Rusu a remarcat că reforma a eliminat posibilitatea ca inspectorii ISU să acorde un avertisment înainte de amendă — și l-a întrebat pe Jurca de ce.
Răspunsul a venit direct și fără menajamente:
„Vă explic principiul din spate. Creștem pragurile, simplificăm, dar când trebuie să vii la masă și nu ai respectat normele, atunci când sunt elemente de pericol, nu mai există varianta unui avertisment. De fapt, ce se întâmpla cu avertismentele? Toată lumea primea un avertisment și era și o formă de corupție, ca să fie foarte clar. Inspectorii primeau inceptive-ul ca să dea avertismentul."
Jurca a mers mai departe, extinzând diagnosticul și la amenzile mici:
„Inclusiv amenzile mici creează un fond pentru o posibilă corupție: «Nu-ți dau amenda mare, îți dau amenda mică dacă ne înțelegem». Așa se întâmplă în realitate, credeți-mă, vin de la nivel local și știu foarte bine toate mecanismele astea. Știu cum nu se rezolvă lucrurile."
Reacția parlamentarilor a venit prompt: „Ne speriați!"
Ce este concret mecanismul descris
Logica coruptivă expusă de Jurca este simplă și, din nefericire, familiară oricui a trecut printr-un proces de avizare în România. Inspectorul ISU sosea la control, constata neconformități reale sau inventate, și în loc să aplice amenda sau să suspende activitatea — consecințele prevăzute de lege — oferea o cale de ieșire: avertismentul. Un document oficial, aparent benign, care îi permitea operatorului să continue activitatea și care, în realitate, era cumpărat. Suma — „o atenție", în limbajul consacrat al birocrației românești — circula discret, fără chitanță.
Prin dublarea pragului de suprafață și eliminarea avertismentului ca instrument de conformare, reforma încearcă să atace simultan volumul de documentații care generează ocazii de corupție și mecanismul prin care inspecția devenea tranzacție.
O paranteză care nu poate fi ignorată: despre „inceptive”
Și totuși, înainte de a celebra transparența cu care un oficial al statului român a descris în fața Parlamentului un focar sistemic de corupție, se impune o observație de ordin lexical.
Breaking News: Guvernul român a anunțat marți eliminarea completă a corupției din sistemul de avize ISU, introducând totodată termenul „inceptive" în vocabularul oficial al administrației publice. „Sistemul este acum complet transparent", a declarat șeful Cancelariei, adăugând că nu știe nici ce înseamnă „transparent" în engleză dar că sună bine.
E aproape jignitor să inventezi un cuvânt atât de anemic într-o limbă care a rafinat arta șpăgii până la nivel de poezie. Limba română oferă un bufet suedez unic de termeni pentru acest sport național: avem „o mica atenție”. Cinstit. Te atenționez că dacă nu-mi dai bani, nu-ți semnez hârtia. Avem „șpăguță”. Alintat. O mică mângâiere pentru birocratul obosit. Avem „protocol”. Elegant. Ca și cum am fi la bal, nu la furat. Sau nepieritorul „să fie bine ca să nu fie rău”. Sunt formule organice, șlefuite de decenii de practică la ghișeu, disponibile gratuit oricui vrea să ungă rotițele sistemului. Rușine, domnule Jurca.
Crescând în România lui Ceașcă, tata considera că orice funcționar care nu lua mită era fie bolnav, fie comunist. Jurca m-a făcut să mă gândesc la tata. Nu pentru că ar semăna cu el — tata, ca orice roman care se respecta, cel puțin știa să spună „mită" corect în trei limbi. Ci pentru că amândoi înțelegeau instinctiv același lucru: că cel mai important nu e ce faci, ci cum numești ce faci. Tata îi zicea „atentie". Jurca îi zice inceptive. Evoluție.
Îl înțeleg pe Jurca. Și eu am trecut printr-o perioadă în care găseam că engleza oferă o distanță confortabilă față de realitățile pe care nu voiam să le numesc direct. Diferența dintre mine și Jurca este că eu am douăzeci și trei de ani și nu sunt șeful Cancelariei unui premier care a făcut din claritate și austeritate morală brandul său personal. Jurca are — estimez — în jur de patruzeci de ani, o funcție de cea mai înaltă responsabilitate, și a ales să descrie mita cu un cuvânt pe care nu îl găsești în Oxford English Dictionary, Merriam-Webster, sau în oricare altul dintre cele aproximativ două sute douăzeci și trei de dicționare engleze care există în lume, număr pe care l-am verificat acum special pentru acest articol și care este, recunosc, posibil inexact, dar cu siguranță mai precis decât definiția lui Jurca pentru „inceptive”.
Senatorul care l-a ascultat și a zis „ne speriați" mi se pare, în retrospectivă, eroul neștiut al acestei povești. Nu pentru curaj — nu a făcut nimic cu observația. Ci pentru că a exprimat, în două cuvinte, exact ceea ce simte orice cetățean român care urmărește procesul de reformă a statului: un amestec ciudat de admirație sinceră că știm exact ce nu merge și resemnare că știința asta nu ne-a ajutat niciodată la nimic.
Contextul mai larg: ISU, avize și tragedia Colectiv
Reforma avizelor ISU nu poate fi disociată complet de contextul în care urgența ei a devenit evidentă. Incendiul din clubul Colectiv din octombrie 2015, soldat cu 65 de morți, a scos la iveală că spațiul funcționa fără autorizație de securitate la incendiu — iar cazul nu era singular. Sistemul de avizare ISU nu a eșuat doar din cauza corupției, ci și din cauza birocrației sufocante care îi împingea pe operatori să caute scurtături, dintre care cea mai costisitoare s-a dovedit a fi tocmai „avertismentul" cu inceptive descris de Jurca.
A durat aproape un deceniu până când un oficial al statului român a spus explicit, în fața legislativului, că mecanismul avertismentului era un sistem de corupție instituționalizat. Că a spus-o cu un englezism inventat nu diminuează greutatea constatării. Că a stârnit în sală reacția „ne speriați" — în loc de tăcerea care însoțește de obicei lucrurile știute de toată lumea — rămâne, poate, semnul cel mai bun că ceva, cât de mic, se mișcă.